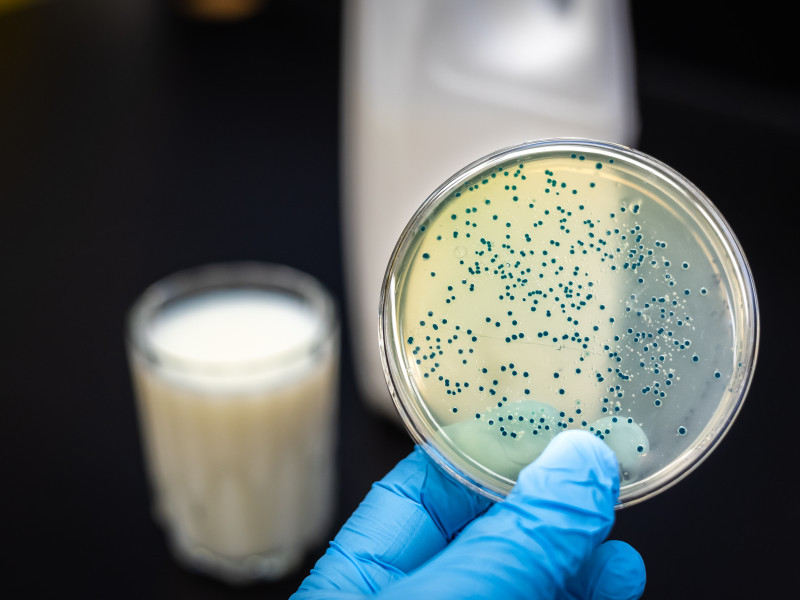

Antibiotic Residues in Food and Feed: Legislation, Case Studies and Laboratory Control
Antibiotics are primarily associated with the feed sector in food production, where they have historically been used for both treatment and prevention of infections in livestock. Due to growing concerns about antimicrobial resistance (AMR), their use is now tightly regulated within the European Union. This article outlines the current legal framework, food safety risks, and laboratory strategies for detection and control.
Legal Framework: Mandatory Safeguards Since EU Regulations 2019/6 and 2019/4
The European Union has imposed strict conditions on antibiotic use in livestock production. Since the implementation of:
- Regulation (EU) 2019/6: prophylactic use of antibiotics in groups of animals is prohibited;
- Regulation (EU) 2019/4: medicated feed may only be manufactured and distributed with a veterinary prescription.
In addition, Regulations (EC) 178/2002, 183/2005 and 767/2009 apply to traceability, hygiene and labelling.
For products of animal origin, Regulation (EU) 37/2010 sets Maximum Residue Limits (MRLs) for pharmacologically active substances. Examples include:
- Tetracycline - Milk: 100 µg/kg
- Enrofloxacin - Beef: 100 µg/kg
- Sulfamethazine - Eggs: Not permitted (0 µg/kg)
Practice: Detection and Exceedance in the Netherlands
According to the NVWA 2023 monitoring reports, antibiotic residues were detected in 2.6% of the tested samples (n=2800) from animal products. Most violations involved imported honey (chloramphenicol) and egg products from non-EU sources.
Example: In 2022, a shipment of chicken breast from Brazil showed a sulfadiazine level of 187 µg/kg, exceeding the MRL of 100 µg/kg. The batch was blocked and withdrawn from the market.
Laboratory Analysis: From Screening to Confirmation
Laboratories test food and feed products for antibiotic residues using validated analytical methods:
- Screening tools: microbial inhibition tests (e.g. four-plate test) and ELISA offer rapid preliminary results.
- Confirmation and quantification: LC-MS/MS remains the gold standard for confirming specific antibiotics and determining concentrations in relation to the applicable MRL.
Food Safety Risks
Residues can be present in food due to incorrect withdrawal periods after treatment or cross-contamination in the supply chain. Key risks include:
- Adverse reactions in hypersensitive individuals (e.g. allergies);
- AMR development through transfer of resistant bacteria or genes to humans;
- Microbiota disruption in the gut due to prolonged low-dose exposure.
Strict compliance with withdrawal periods and residue limits is essential to mitigate these risks.
Feed Sector: From Risk to Control
In the animal feed chain, antimicrobial substances are prohibited unless the feed is classified as veterinary medicinal feed. Control measures include:
- GMP+ FSA certification: risk-based monitoring for prohibited substances;
- SecureFeed: mandatory in many retail and producer chains; checks include carry-over in production lines;
- Manure testing: may reveal traces of antibiotics, indicating indirect inclusion in feed.
Example: In 2021, a producer found tylosin traces in returned broiler feed. Further analysis revealed contamination due to insufficient cleaning between a medicated batch and standard production. Since then, mandatory rinse cleaning protocols have been introduced for batch transitions.
Risk Assessment and Follow-up
If residue levels exceed MRLs:
- RIVM or NVWA conducts a risk assessment based on the Acceptable Daily Intake (ADI);
- Products are blocked from sale;
- Counter-analysis via an independent laboratory is required.
Conclusion
Antibiotic residues are legally restricted, analytically traceable and manageable across the supply chain - provided laboratory control, hygiene protocols and prescription rules are strictly upheld. Systematic monitoring through GMP+, NVWA and certified labs remains crucial to protect public health and ensure the export eligibility of the food supply chain.
Meld je aan voor de laatste tips en adviezen dat je gelijk in de praktijk kunt brengen.